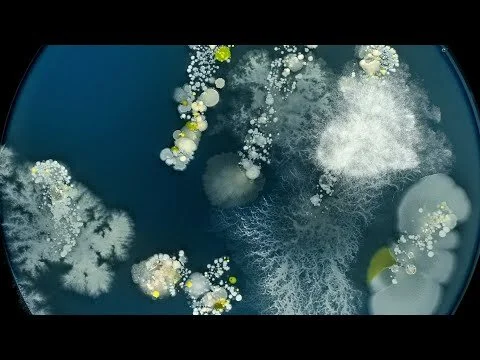

Director | Co-Producer 2017
Voguing has come a long way since 1990’s seminal Documentary Paris is Burning. It is experiencing a renaissance in Europe, with the heart of the scene in Paris. Sky Ninja is a part of the new generation keeping the torch burning and helping pass it on to the next.
--
Credits:
Director: Nick Rowley
Producer: Meshach Falconer Roberts, Nick Rowley
Cinematography: Nye Williams, Matt Dadson & Nick Rowley
Colourist: Richard Jephcote
--
Previous screenings:
World Premiere: BFI Flare Film Festival London March 2017 - Shadow and Act short film programme.
#FiveFilms4Freedom 2017 - Selected for the British Council initiative promoting equality and diversity. Still Burning was one of 5 films shared around their global network receiving over 100,000 views online between March 16th and 26th.
26th May 2017 - Kashish Mumbai International Queer Film Festival, Mumbai, Liberty Cinema
1st June 2017 - Outgames, Miami - SoundScape Park at the New World Center
17th June 2017 - Mix Milano Festival
#fivefilms4freedom US tour
November 1st at 18:00 - Washington DC
November 9th at 17:30 - Orlando, The Abbey
November 13th at 17:30 - LA, UCLA Dodd Hall
November 16th at 18:00 - NY, Barclays ASK Auditorium
November 5th at 16:15: MIX Copenhagen - Cinemateket, Gothersgade 55, Copenhagen
November 19 at 17:00: Fringe! Queer Film and Arts Fest, All Born Superstars: Everyday Queer Performance - HACKNEY SHOWROOM, Hackney Downs Studios, Amhurst Terrace, London
Feb 25th 2018: Mardi Gras Film Festival Sydney
March 19th: Queerly Beloved, The Miller, London